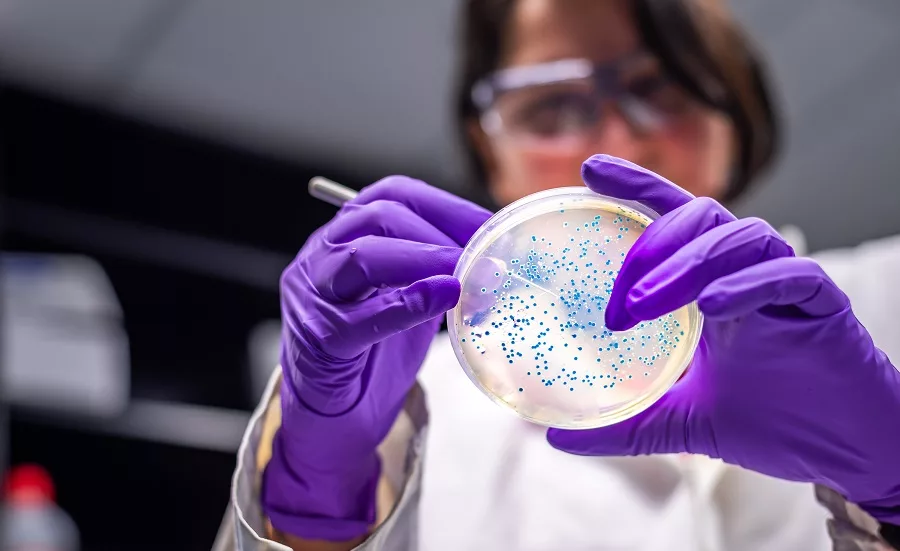

Sponsored Content
The Good, The Bad, & The Microbial
When you think back on your high school days, do a string of nostalgic Kodak moments flash through your mind? The infamous senior trip. Pep rallies. Friday night football games. An inspiring teacher that helped set the trajectory for your life (O Captain! my Captain!) Prom. Science class. No, wait, even better—microbiology. Yeah, those were the good old days.
[crickets]
What? Really? No one is with me on missing microbiology?
Well, for me (a bit of a nerd), microbiology, the study of small living things called microbes or microorganisms invisible to the naked eye, was one of my favorite subjects. Want to know why?
For starters, microbes are diverse and ubiquitous—meaning they can be found almost everywhere. In fact, wherever there’s sufficient water and nutrients for growth, there will be microbes. They’re found in soil and dust; in water; in both animals and humans, as well as in many foods and beverages.
But what really interested me, was their importance to the food and beverage industry. Microbes like yeasts, molds, and bacteria present an invisible challenge to these industries. If left to grow unchecked in food and beverage products, they can be both destructive and dangerous.
For example, the effects of ‘bad’ bacteria can be seen in common manifestations such as sour milk, putrid meats, swollen cans, and off-flavor juices. Nothing you want to encounter in something you’re drinking or eating.
Now, before you go out and rid the world of all bacteria, microbes, etc., let me tell you about the other side of things. Yes, microbes tend to have a bad reputation, but they also help create some of the most amazing foods known to mankind! Cheese, yogurt, sourdough, pickles, enzymes, preservatives, and probiotics would not exist without microbes. Can you imagine a world without cheese?
Another example of ‘good’ microbes is the yeast species Saccharomyces cerevisiae —used in baking and fermented alcoholic beverages for thousands of years—which gives us bread, wine, and beer. And kefir, an ancient probiotic beverage made from a bacteria and yeast culture called kefiran, is a delicious drink that offers many health benefits due to its microbial content.
Come on, doesn’t this incite some curiosity? Don’t you want to know more about this fascinating subject?
Even if many years have passed since your high school glory days, it's not too late to start learning again! Be a lifelong learner. Never stop. The benefits are numerous—an enhanced understanding of the world, open doors to new opportunities, improved quality of life—and more online programs are making this transition easier for the busy professional. Our online courses use a technique called micro-learning that breaks up difficult topics and arranges them into bite-sized lessons for the learner to engage with on any device. Lessons take the form of infographics, quick readings, videos, animations, discussions, and interactive slides. This unique delivery method empowers you to complete courses on your schedule, at your own pace. Short, focused sessions can help avoid mental burnout and cater to adult learning styles. All paving the way for successful integration back into the world of learning.
If you’re up for the challenge and ready to dive into the basics of microbiology and its role in the food and beverage industry, we’ve got the course for you! Introduction to Microbiology will teach you the different types of microbes, factors affecting microbial growth, spoilage control, pathogenic impacts and indicators, commensal microbes in beverages,
microbial control strategies, Good Manufacturing Practices (GMP) and sanitation, and last but not least, biofilms.
What are you waiting for? Stand on your desk, sound your barbaric yawp o’er the rooftops of the world, and click the link to start learning. Maybe we'll even throw a virtual prom for you.
Looking for a reprint of this article?
From high-res PDFs to custom plaques, order your copy today!




